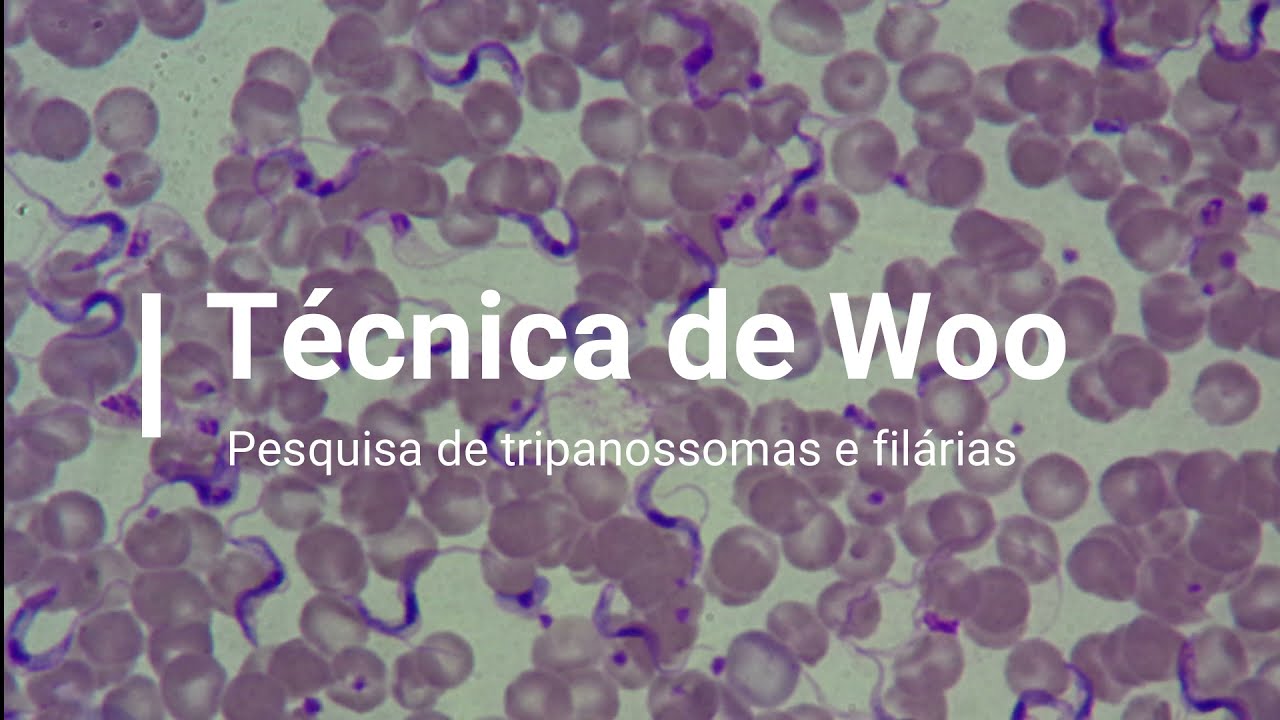
Técnica de Woo

Técnica de Woo
Автор: Rovaina Doyle
Загружено: 2022-01-12
Просмотров: 1781
Описание: Para pesquisa de tripanossomas e filárias
Повторяем попытку...
Доступные форматы для скачивания:
Скачать видео
-
Информация по загрузке:
![[COMO HACER BIEN] FROTIS O EXTENDIDO DE SANGRE [GOTA GRUESA] para [DIAGNOSTICO] de HEMOPARASITOS😊](https://image.4k-video.ru/id-video/Dt14HKcbW2M)













![[Parasitologia] Métodos Coproparasitológicos: Técnica de Faust e cols](https://image.4k-video.ru/id-video/ATP_mWaiTOY)




